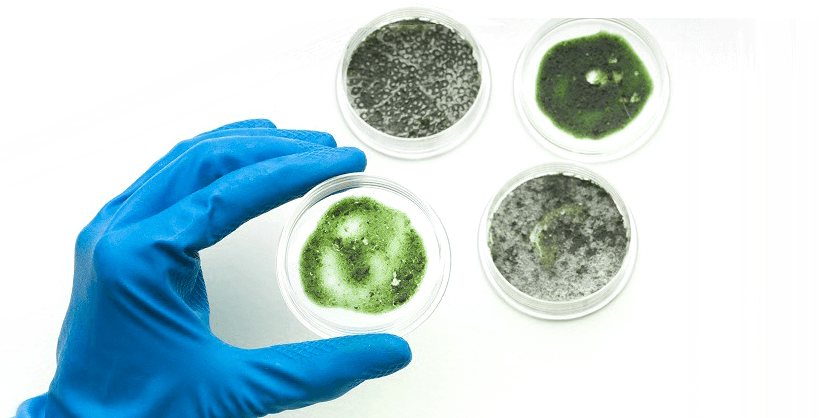
about-image

Wilmer Environmental, LLC
Odell Wilmer is a Biologist , trained and certified, over 30 years of service. Certified Microbial Remediation Supervisor Study NAETI-2005. Current Understanding & Advances in Mold Assessment, Sampling &Analysis-AEROTECH P&K 2005. Certified Microbial Consultant Study NAETI . Indoor Air Quality & Fungal Spores-Part 1 and Part 2 McCrone Research Institute 2004 and 2006 Chicago, IL.
How Is The Air Quality In You Home?
Give us a call here at Wilmer Environmental, Inc. We will take care of you.

MOLD TESTING

